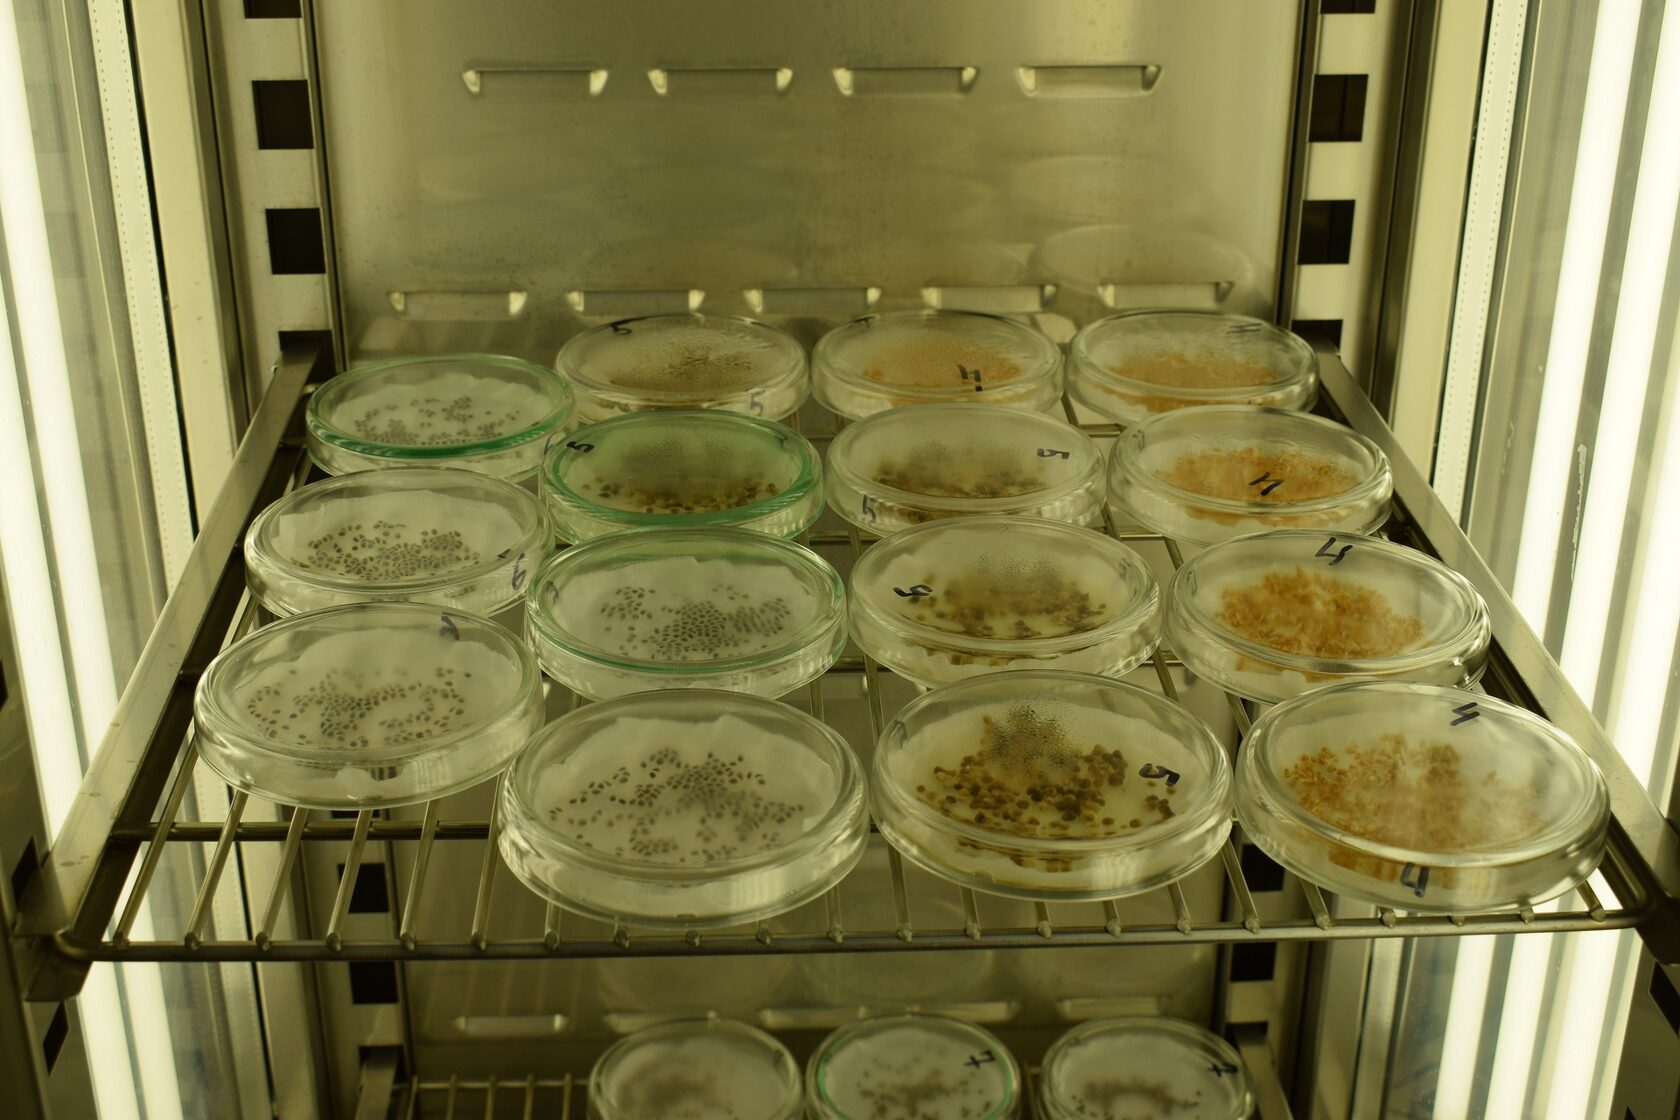

Большое количество витаминов А, В, С, Е и других содержится в микрозелени ряда культурных растений. Ее можно выращивать как в промышленных масштабах, так и в домашних условиях для личного употребления
Вопросы здорового питания давно вошли в топ наиболее актуальных для современного человека. В Вятском государственном университете они нашли отражение в стратегическом проекте «Технологии здоровья» программы «Приоритет-2030», в рамках которого осуществляется масштабная научно-исследовательская работа по разным направлениям.
Недавно сотрудники научно-образовательного центра «Ботанический сад» ВятГУ подвели итоги важного этапа исследования микрозелени культурных растений.
Мария Скоробогатая, младший научный сотрудник НОЦ «Ботанический сад», рассказала:
Повышение значимости здорового питания, развитие сити-фермерства породили интерес к микрозелени – молодым нежным проросткам растений различных видов, съедобная часть которых представлена стеблем, семядольными листьями и зачатками первых настоящих листьев. В зависимости от темпов развития они могут быть собраны через одну-три недели после посадки. Несмотря на свой небольшой размер, микрозелень обеспечивает широкий спектр вкусов и ароматов, разнообразной цветовой гаммы и разной текстуры. Сегодня микрозелень выращивают и используют в кулинарии по всему миру, ассортимент насчитывает десятки различных культур. Возрастающая популярность этого продукта связана, прежде всего, с полезными свойствами молодых побегов растений и простотой их выращивания.
Вместе с тем, подчеркнула Мария Николаевна, компонентный состав микрозелени многих видов не был глубоко и всесторонне исследован.

Микрозелень горчицы
В НОЦ «Ботанический сад» провели оценку содержания витаминов в микрозелени пяти видов культурных растений: кресс-салата, горчицы, гороха, моркови, редиса. Микрозелень была предварительно выращена в пластиковых контейнерах на подложке из нетканого вискозного материала в условиях климатической камеры с программой, моделирующей естественные условия суточных циклов. Сбор образцов прошел после массового раскрытия семядольных листьев, повторяясь через день до достижения коммерческой зрелости продукта. Собранные образцы были заморожены при температуре около -18оС и хранились в таком состоянии до проведения анализа с использованием специального оборудования.

Микрозелень кресс-салата
Результаты исследования позволяют говорить о большом количестве витаминов в микрозелени культурных растений. Так, кресс-салат богат витамином С, поэтому его можно рекомендовать для повышения иммунитета в сезон простуд. Витамин Е содержится в том же кресс-салате, а также в горчице, лютеин – в моркови, витамин К – в редисе, витамины группы В – в горохе в начале его прорастания, -
сообщила М.Н. Скоробогатая.
Проведя анализ компонентного состава, исследователи усложнили задачу, сосредоточив внимание на динамике изменения содержания витаминов на разных этапах развития микрозелени.
Важно понимать, на каком этапе развития концентрация того или иного витамина максимальна. Это позволит подобрать наиболее оптимальные параметры для выращивания микрозелени, разработать рекомендации по срокам ее употребления, -
пояснила Мария Скоробогатая.

Микрозелень моркови
Результаты исследования опубликованы в научном журнале «Химия растительного сырья». Очевидно, что выводы, сделанные учеными ВятГУ, могут быть использованы как для бизнес-стартапов, так и для создания домашних огородов микрозелени.
В НОЦ «Ботанический сад» ВятГУ продолжают исследование микрозелени: помимо культурных растений, внимание ученых привлекли дикорастущие.

Микрозелень редиса
